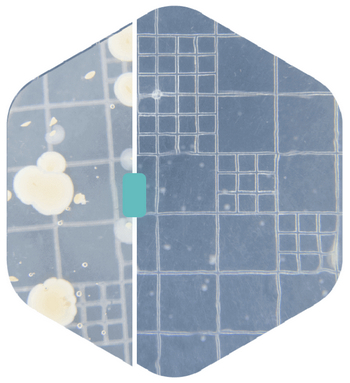

Sonovia’s disruptive ultrasonic-based technology is redefining textile finishing
Sonovia was founded in 2013 by leading Israeli professors and scientists following over 10 years of research at Bar Ilan University. A successful 4-year EU-funded research was carried out to fight hospital-acquired infections and to protect people from the transmission and dangers of viruses and infections.
Sonovia develops and offers a range of industrial solutions based on a licensing agreement with Bar-Ilan University to commercialize its patents. Sonovia’s disruptive sono-based technology helps save lives and improve quality of life through built-in active protection of textiles. The company offers commercial solutions that are sophisticated, sustainable, green, and, most importantly, save lives keeping people safe from viruses and bacteria.
Sonovia’s commercial eco-friendly sono-based technology blasts nanoparticles onto textiles at high velocities, achieving durable embedded properties. The sound wave technology is used – via eco-friendly processes – to embed desirable long-lasting, highly effective properties that become integral to the textile. The process has been scientifically tested and proven to retain its efficacy and added-value for over 55 washes. The treated textiles have active built-in protection against viruses, bacteria, fungi and odor with a proven neutralizing success rate of over 99%.
The sono-based technology uses only eco-friendly materials and 0 chemical binders in the manufacturing process, protecting water sources and environment. Sonovia claims their products are reusable, washable, and maintain their properties for at least 55 wash cycles. In an industry that is a leading cause of pollution worldwide, Sonovia’s innovative technology eliminates the need for harmful chemicals, dramatically reduces water consumption, and is safe for humans and the environment.
Sonovia is currently collaborating with industry leaders across multiple sectors including the apparel, automotive, locomotive, hospitality and medical companies to evolve textile performance to additional fields such as UV-protection, water-repellency, and fire-retardancy.
“Our chemical formulations are all water-based, no chemical binders or other harmful materials are used.”
BEFORE
|
|
AFTER
|
PARTNER WITH US
Sonovia is working in cooperation with the biggest names in the industry, towards revolutionizing the textile industry. We are looking to cooperate with leading brands OEMs and textile finishers from across the globe as well as with brilliant specialty chemistry innovators. If you find that your company could partner with us to create safer and better products, contact us at
